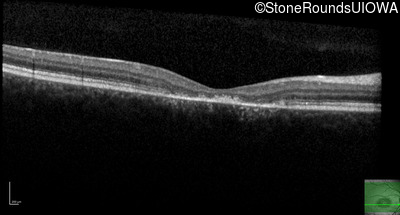
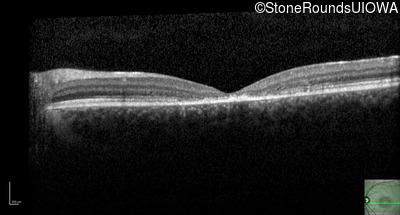
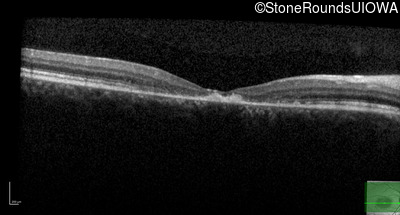
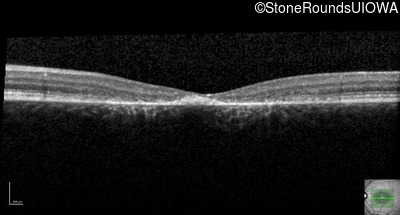
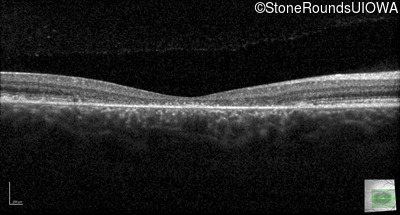
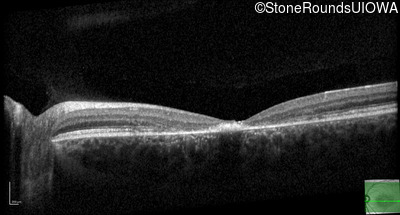
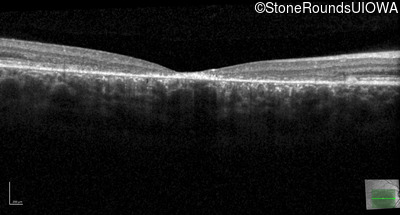
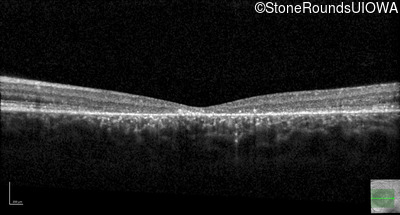
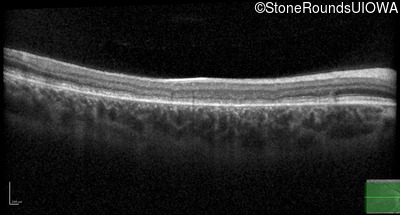
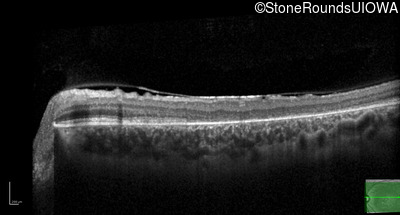

Case
SR1859
Student Mode
AR Stargardt Disease (IIA)
Female
Female
Hidden
SR1859
Student Mode
AR Stargardt Disease (IIA)
Female
Female
History
This 16 year old female first had difficulty seeing the blackboard at age 9. Her eye doctor at the time felt at the time that she was "faking it". More recently her eye doctor told her she would be blind by age 20 and suggested she get a seeing eye dog.
| Age at visit: 16 years |
| Age at visit: 17 years |
| OD | OS | ||
|---|---|---|---|
| OD | OS | ||
|---|---|---|---|
| OD | OS | ||
|---|---|---|---|
| Age at visit: 18 years |
| OD | OS | ||
|---|---|---|---|
| OD | OS | ||
|---|---|---|---|
| OD | OS | ||
|---|---|---|---|
| Age at visit: 22 years |
| OD | OS | ||
|---|---|---|---|
| OD | OS | ||
|---|---|---|---|
Diagnosis & molecular findings
| Disease | Gene | Allele 1 variant(s) | Allele 2 variant(s) | Inheritance mode |
|---|---|---|---|---|
| AR Stargardt Disease | ABCA4 | Asp507Tyr GAT>TAT | IVS40+5 G>A | AR |
Disease:
Gene:
Allele 1:
Asp507Tyr GAT>TAT
Allele 2:
IVS40+5 G>A
Inheritance:
AR